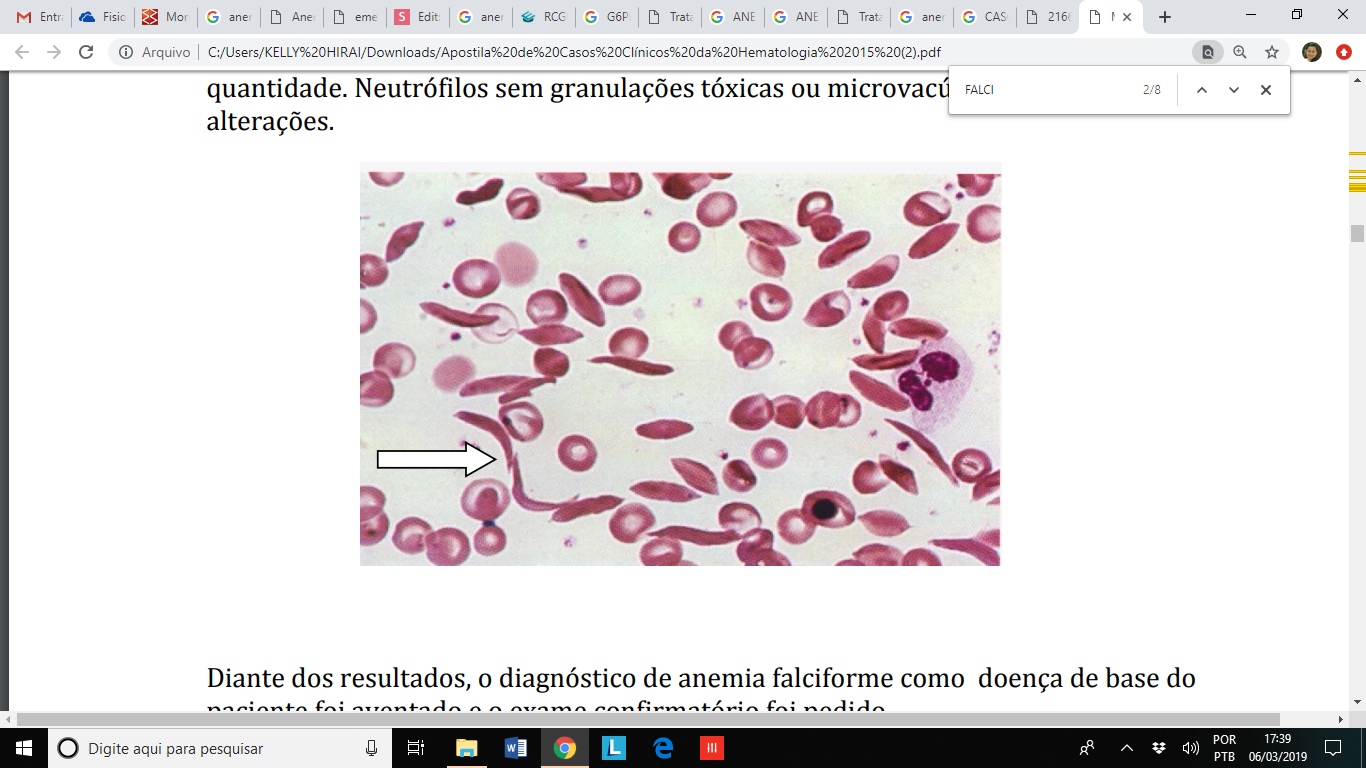
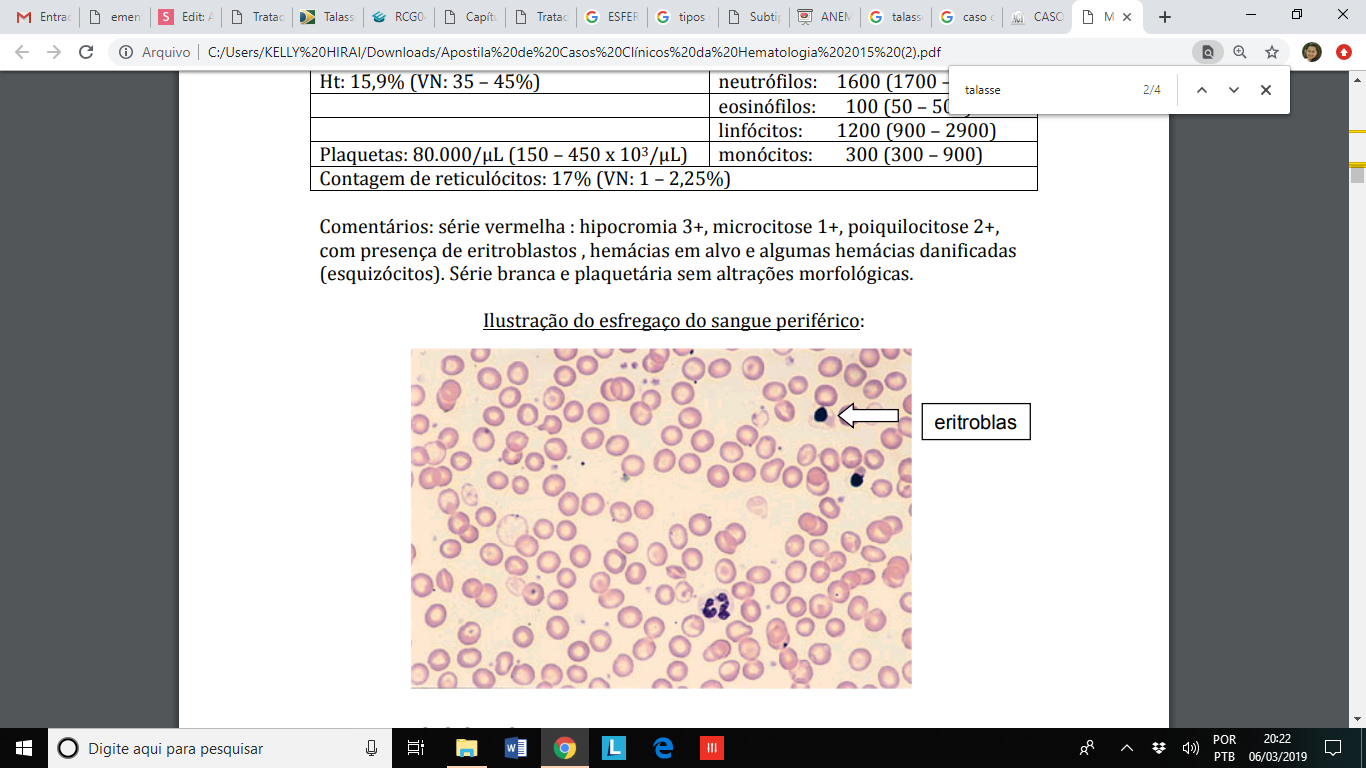
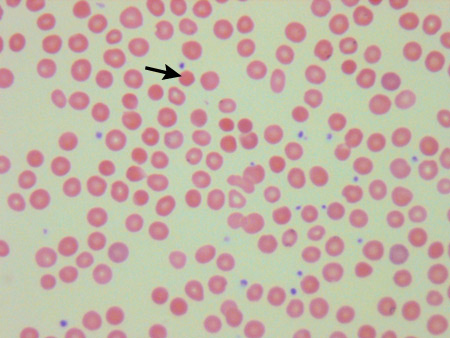
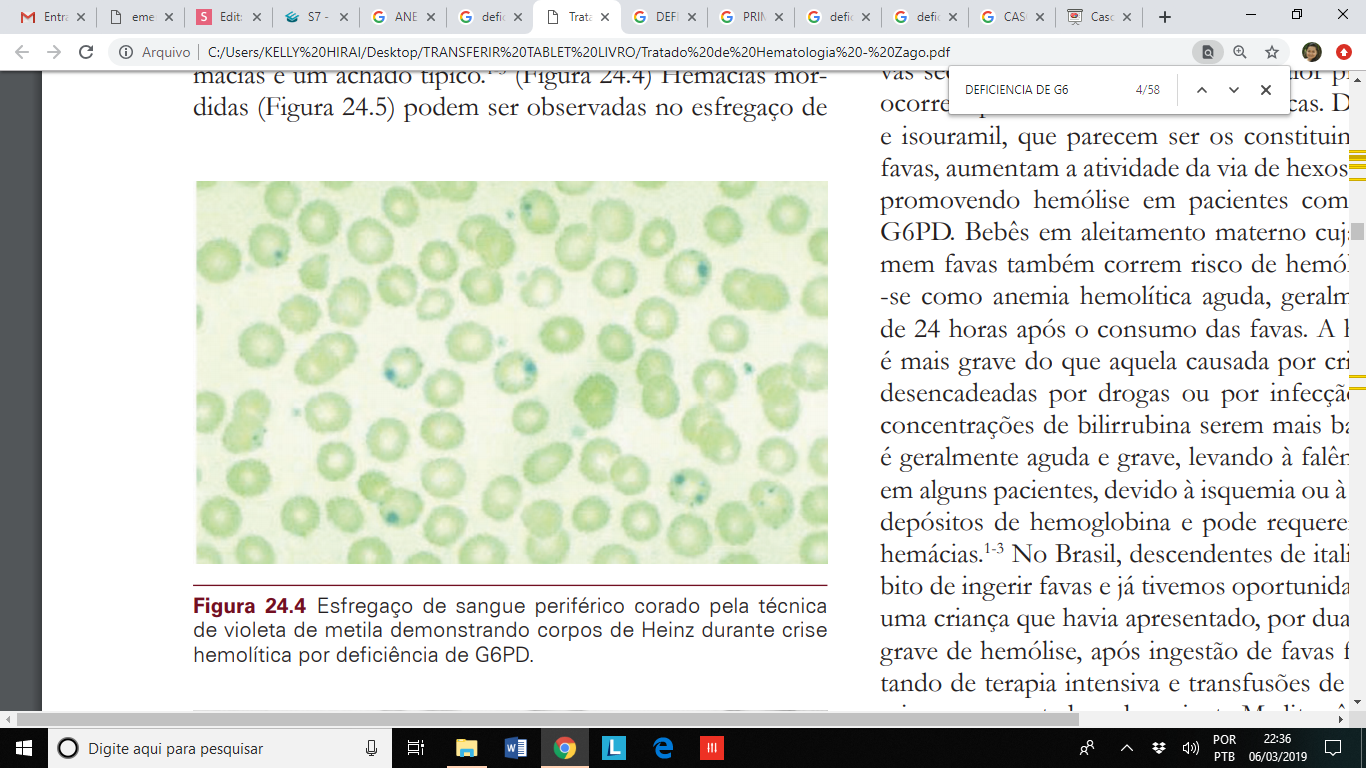

ANEMIAS HEREDITÁRIAS
ANEMIAS HEREDITÁRIAS

ERITRÓCITO
DEFEITOS NA HEMOGLOBINA (ANEMIA FALCIFORME E TALASSEMIAS)
DEFEITOS NA ENZIMA (GLICOSE-6-FOSFATO DESIDROGENASE)
DEFEITOS NA MEMBRANA (ESFEROCITOSE)






Microscopia eletrônica de eritrócitos com oxiHb S


TESTE DE FALCIZAÇÃO DE HEMÁCIAS
CASO CLÍNICO
PACIENTE: Homem, 19 anos, mulato, natural do interior da Bahia e procedente de Barrinha (SP), desempregado.
QUEIXA: O paciente refere que, há cerca de 3 dias, começou a sentir dores em membros inferiores. As dores nas pernas se iniciam de forma abrupta e progressiva. Hoje, pela manhã, fez um hemograma em sua cidade e foi constatado anemia grave. Foi encaminhado a este serviço para investigar a causa da anemia e da dor em membros inferiores. No momento da admissão na Unidade de Emergência, referia dores em membros inferiores de forte intensidade. Referia que desde criança sentia dores pelo corpo esporadicamente, semelhante ao quadro atual.

PRESENÇA DE DREPANÓCITOS OU HEMÁCIAS EM FORMA DE "FOICE"
ELETROFORESE DE HEMOGLOBINA

Conhecidas como “Anemia do Mediterrâneo”. Talassemia deriva da combinação das palavras gregas thálassa, para “mar“, e haema para “sangue”.
Talassemias são hemoglobinopatias quantitativas, hereditárias, genéticas, decorrentes de mutações nos genes das globinas (alfa (cromossomo 16) ou beta-(cromossomo 11) na maioria dos casos), que promovem redução ou ausência de síntese de uma ou mais das cadeias de globina, formadoras da hemoglobina.





Beta talassemia
Alteração quantitativa na síntese de globinas beta.



Caso clínico
PACIENTE: 10 anos, sexo feminino, branca, natural e procedente de Araraquara, estudante.
QUEIXA: A mãe da criança refere que, desde o nascimento, a criança apresenta anemia grave, necessitando de transfusões esporádicas ao longo dos anos. Refere que a causa dessa anemia nunca foi descoberta e que sua filha também possui baixa estatura e alterações na face. Além disso, não consegue brincar e fazer exercícios como as outras crianças pois se cansa rapidamente. Quando fica cansada no repouso, procura assistência médica e recebe transfusão sanguínea.

A esferocitose hereditária (EH) é uma anormalidade hereditária dos eritrócitos, causada por defeitos nas proteínas estruturais da membrana.
A condição é hereditária dominante em 75% das pessoas. A gravidade do distúrbio está relacionada ao tipo e tamanho do distúrbio da membrana, que são determinados geneticamente.
QUATRO TIPOS DE DEFEITOS
DEFICIÊNCIA DE ESPECTRINA
DEFICIÊNCIA COMBINADA DE ESPECTRINA E ANKIRINA
DEFICIÊNCIA ISOLADA DA BANDA 3
DEFICIÊNCIA DA PROTEÍNA 4.2


As células anormais são esféricas.
Elas são removidas pelo baço, resultando em uma meia-vida eritrocitária reduzida.
A gravidade da hemólise varia entre indivíduos diferentes, e pode ser exacerbada por infecções.
A EH está associada com esplenomegalia (comumente), anemia (variavelmente) com uma contagem elevada de reticulócitos e icterícia (ocasionalmente).


PARÂMETROS LABORATORIAIS E CLASSIFICAÇÃO DA ESFEROCITOSE HEREDITÁRIA

Um adolescente foi admitido no hospital com fraqueza generalizada, dor de garganta, icterícia e dor no abdome. Estava ligeiramente febril há vários dias e tinha observado que a cor da sua urina tinha fi cado escura. Sua temperatura era de 38°C. O médico encontrou ao exame físico, além da conjuntiva pálida e ictérica, a mucosa da faringe inflamada, gânglios cervicais e esplenomegalia (aumento do baço) moderada. Os exames de laboratório indicaram anemia hemolítica com valor de hemoglobina de 9g/dL (valores normais entre 14 e 18), 10% de reticulócitos (valores normais < 2,4%) e bilirrubina sérica de 100µmol/L (valores normais de 3,4 -20,5µmol/L). O esfregaço sanguíneo mostrava anisocitose (tamanho variável das hemácias) moderada e aumento do número de microesferócitos (hemácias globulares pequenas).
DEFICIÊNCIA DE GLICOSE-6-FOSTATO DESIDROGENASE (G6PD)
A glicose-6-fosfato desidrogenase (G6PD) é uma enzima importante no metabolismo das células e exerce um papel especial na manutenção e preservação dos eritrócitos.
A G6PD atua no mecanismo antioxidante destas células e mantém o seu ciclo vital.
A deficiência de G6PD geralmente se manifesta através de anemia hemolítica induzida por infecção ou por drogas.
Qualquer que seja a causa da hemólise aguda na deficiência de G6PD, esta costuma se manifestar clinicamente através de fadiga, dor nas costas, anemia, icterícia e colúria

ANEMIAS HEREDITÁRIAS
By KELLY EMI HIRAI
ANEMIAS HEREDITÁRIAS
- 1,926